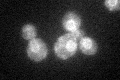
YJR010C-A
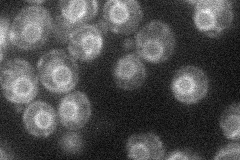
YJR010C-A
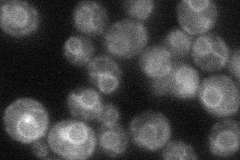
YJR010C-A
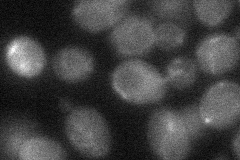
YJR010C-A
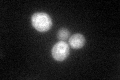
YJR010C-A
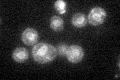
YJR010C-A

View description
Subunit of the signal peptidase complex (SPC), which cleaves the signal sequence from proteins targeted to the endoplasmic reticulum (ER), homolog of the SPC12 subunit of mammalian signal peptidase complex
Localization:
Intensity:
Fold change:
Significance:
-
C’ GFP library in SD
ER34.78 -
N' NOP1pr-GFP in SD

ER49.842 -
N' TEF2pr-mCherry in SD
ER17.729 -
N' NATIVEpr-GFP in SD
ER32.3115 -
N' TEF2pr-VC and Cyto-VN in SD
below threshold27.35 -
C’ GFP library in SD+DTT
ER38.71.11No -
C’ GFP library in SD+H2O2

ER32.580.93No -
C’ GFP library in Starvation Media
ER42.41.21No -
C’ GFP library on the background of Pup2-DaMP

ER -
C’ GFP library on the background of CCT mutant

ER28.57210.82146No
